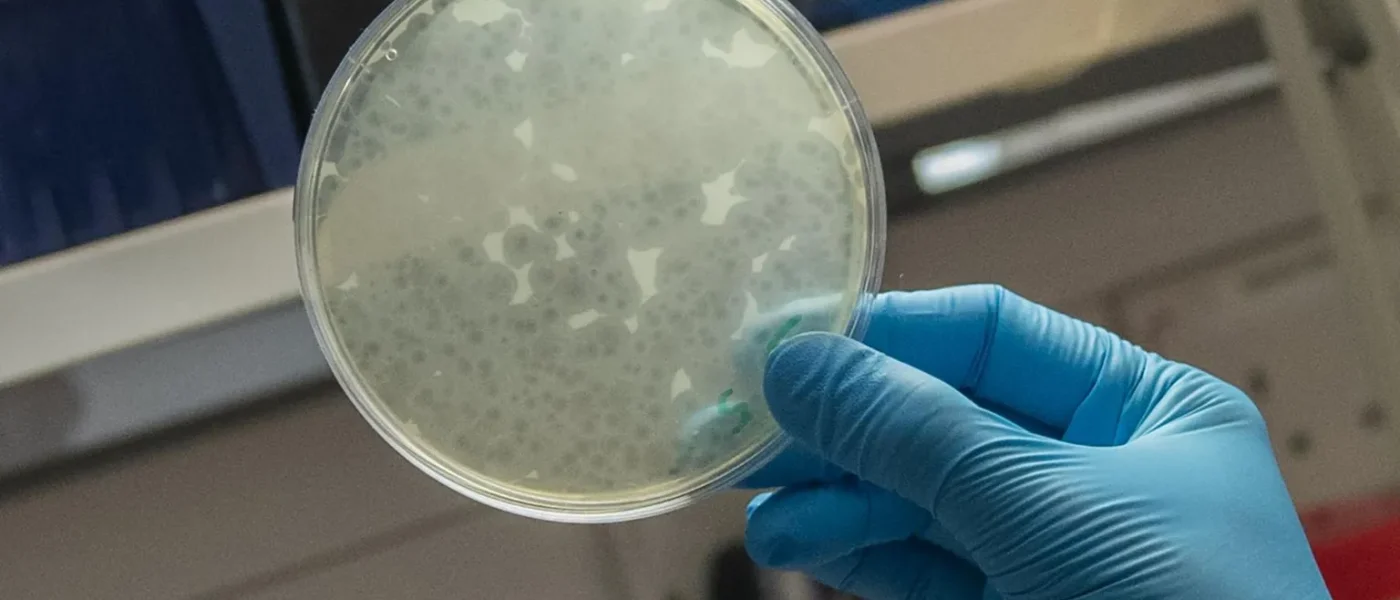
Vírus ‘do bem’: a caça ao inimigo das superbactérias no seu banheiro

Pré-diabetes: controle já e corte risco cardíaco pela metade!
Nova pesquisa revolucionária mostra que controlar o açúcar no sangue em casos de pré-diabetes pode reduzir o risco de morte por doenças cardíacas em impressionantes 50%. Uma esperança real para a saúde cardiovascular de milhões.